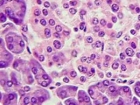
<p>Acini is dark purple, islets are the lighter purple</p>

1/14
Looks like no tags are added yet.
Name | Mastery | Learn | Test | Matching | Spaced | Call with Kai |
|---|
No analytics yet
Send a link to your students to track their progress
Pituitary gland
secretes hormones which regulate some of the most essential controlled parameters of the body, including- water, electrolyte balance, metabolic rate + production.
Has 2 half’s, anterior lobe (epithelial tissue, 6 hormones: TSH thyroid stimulating hormone, ACTH adrenocorticotropic hormone, FSH follicle stimulating hormone, LH luteinizing hormone, GH growth hormone, and prolactin.) and posterior lobe (nervous tissue, 2 hormones: Oxytocin and ADH antidiuretic hormone or vasopressin)

Hypothalamus
Controls the secretion of hormones from the 2 lobes of the pituitary gland in different manners. Secretin of releasing or inhibiting hormones from this regulates the secretion of 6 different hormones from anterior pituitary gland. Actions potentials from this stimulate the secretion of 2 hormones from posterior pituitary gland.

Thyroid gland
The largest pure endocrine gland of the body. Found wrapped around the windpipe or trachea. Inferior to the larynx or voice box. Secretes 2 forms of thyroid hormone, thyroxine know as tetraiodothyronine (T4) and triiodothyronine (T3). Both hormones are stimulated by TSH from anterior pituitary gland, which increase heat generation. Left and right lobes connected by isthmus.

Follicular cells

Thyroid gland under microscope

Parafollicular cells (C cells)

Thyroid follicle

Isthmus
connects the two lobes of the thyroid gland

Pituitary gland under microscope

Trachea
Also known as windpipe, connects larynx to the bronchi of the lungs- allows passage of air

Larynx
Voice box, plays a crucial role in breathing, sound production, and protecting the trachea against food aspiration. It houses the vocal cords, which manipulate pitch and volume, allowing for speech. It is also involved in the cough reflex and is primarily composed of cartilaginous structures held together by ligaments and membranes. Additionally, it serves as a passageway for air between the pharynx and trachea

Parathyroids
four tiny endocrine glands behind the thyroid that regulate blood calcium levels through parathyroid hormone (PTH).

Parathyroid gland under microscope

Adrenal gland under microscope
Darker is cortex and lighter is medulla

Pancreas under microscope
Acini is dark purple, islets are the lighter purple